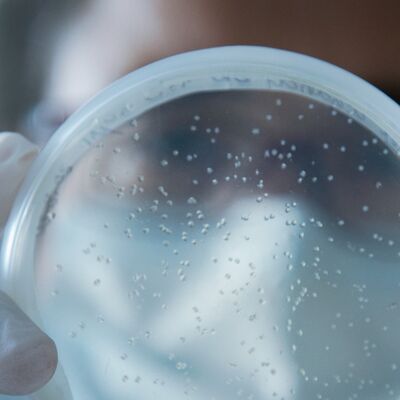

Cancro da mama: uma procura constante por respostas
No Mês Internacional da Luta contra o Cancro da Mama, o Instituto de Medicina Molecular lança o iMM-Laço Hub, um projeto inovador que junta médicos e cientistas com o objetivo de encontrar soluções para a deteção e tratamento da doença. Sérgio Dias e Mariana Matos, respetivamente consultor cientifico e coordenadora do iMM Laço Hub, falaram com a Máxima.